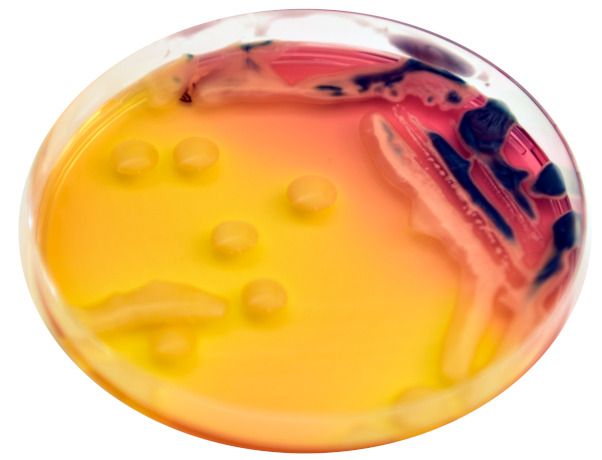
Bacillus megaterium

Talivilja täiendväetamine umbrohutõrjel
Muld on põllumehe peamine töövahend, mistõttu on oluline hoida see terve ning produktiivsena. Kui toetame mulla mikrofloorat, loome taimedele soodsama kasvukeskkonna. Herbitsiidiga paagisegusse sobivad hästi mitmed mulla omadusi parandavad ning taimede kasvu ja arengut soodustavad tooted.
Tulemuseks on taimestiku ühtlasem tärkamine, hästi arenenud juurestik ja taimede kiirem algareng. Eelnevate aastate sügised on selgelt näidanud, et taimede algarengu toetamine tuleb igati kasuks. Kui taimed sügisel põllul ühtlaselt tärkavad ja kasvatavad sügavale ulatuva juurestiku, siis on ka talvitumine edukam ning kevad-suviste heitlike ilmastikuoludega toimetulek parem.
BioSpektrum sisaldab kasulikke mikroorganisme. Toote kasutamisel paraneb mulla bioloogiline aktiivsus ja struktuur, makro- ja mikroelementide omastatavus, taimede stressitaluvus ja haiguskindlus. Mulla koostises ei ole kõik elemendid taimedele koheselt kättesaadavad. Mikroorganismid osalevad mineralisatsiooni protsessis, näiteks eritavad tootes sisalduvad bakterid mulda sekreete, mis aitavad olulisi toiteelemente taimedele mullast omastatavaks muuta. Oma elutegevuse käigus eritavad mikroorganismid mulda ka antibiootilisi aineid, mis aitavad eemale hoida mulla kaudu levivaid patogeene.
Lisaks sisaldab BioSpektrum mükoriisaseeni, kes toimivad juuresüsteemi laiendusena, suurendades juurte imamispinda 50-100 korda. See võimaldab taimedel kuni 50 korda sügavamatest mullakihtidest vett kätte saada. Mükoriisa sümbioos juuresüsteemiga aitab põuatingimustes taimede kasvu aktiivsena hoida umbes 2 nädalat kauem. Mükoriisaseened toodavad ka mullaliimi – glükoproteiin-glomaliini, mis kleebib väikesed mullaosakesed suuremateks agregaatideks, parandades seeläbi mullastruktuuri. Paraneb mulla õhustatus ja veesidumisvõime.
BioSpektrumi mõju taimedele ja mullale on pikaajaline. Kuna mikroorganismid moodustavad spoore, mis ei ole tundlikud ebasoodsate keskkonnatingimuste suhtes, siis jätkub mikroorganismide positiivne mõju ka kevadel.
Mõned näited tootes sisalduvate bakterite funktsioonide kohta:
Bacillus megaterium – fosfaate lahustav bakter, kes eritab happelisi ensüüme (fosfataasi ja fütaasi), mis muudavad fosfori lahustumatutest ühenditest lahustuvateks.
Bacillus mucilaginosus – bakter, kes aitab lahustada kaaliumi, räni ja ka fosforit.
Bacillus mycoides – bakter, kes lahustab mullakivimitest biofungitsiidsete omadustega ränidioksiidi.
Bacillus megaterium
Bacillus megaterium Bacillus mycoides
Bacillus mycoidesBioSpektrumit võib kasutada enne pindmist mulla harimist, enne külvi või pärast külvi segus tärkamiseelsete või -järgsete herbitsiididega kulunormiga 0,25 kg/ha. Oluline on asjaolu, et pritsimise ajal ei kataks taimik veel kogu mulla pinda ega takistaks toote jõudmist mullale.
Humistari näol on tegemist huumushappeid sisaldava mulla huumusseisundi parandajaga, milles on sobivas suhtes humiin- ja fulvohapped. Hapete suhe tootes on ligilähedane põllumulla koostisele. Humistar aitab kaasa mulla orgaanilise aine lagunemisele, rikastab mulda toiteelementidega, muudab fosfori raskesti lahustuvad ühendid taimele kättesaadavaks, parandab mulla õhustatust ja vee sidumisvõimet ning stimuleerib taimede juurekava arengut.
Kui võrrelda Humistari orgaanilise väetisega, siis on Humistar humiinhapete sisalduse poolest 20 korda kontsentreeritum. Kulunorm on Humistari puhul tunduvalt väiksem kui orgaanilise väetise puhul. Mõjuaegu võrreldes avaldub Humistari efekt mulla viljakusele kordades kiiremini.
Soovitame Humistari kombinatsioonis Ruter AA'ga, kuid oluline on jälgida, et taimik ei kataks pritsimise hetkel kogu mullapinda ega takistaks Humistari jõudmist mullale. Koos manustatuna soodustab Humistar taimedel ka Ruter AA's sisalduvate elementide omastamist.
Ruter AA sisaldab vabu aminohappeid ja taimede arenguks ning kasvuks vajalikke makro- ja mikroelemente. Vabad aminohapped soodustavad narmasjuurte arengut. Taimed on võimelised toitaineid ja vett paremini kätte saama. Aminohapete arginiini ja metioniini ning orgaaniliste ainete toimel imenduvad toitained kiiresti läbi rakuseinte. Tänu aminohapete võimele liita metallioone paraneb toiteelementide imendumine ja edasikandumine taimes. Taimed muutuvad vastupidavamaks liigniiskusele, taimehaigustele ning pestitsiidide võimalikele kõrvalmõjudele. Nad ei pea ebasoodsates kasvutingimustes kulutama täiendavat energiat valkude sünteesiks. Fosfor ja kaalium ergutavad juurestiku kasvu, suurendades narmasjuurte arvukust ja mõõtmeid.
Kui taimed on tärganud ja veidi lehemassi kasvatanud (alates 2. lehest), siis elemendid, millele taliteraviljade puhul sügisel tähelepanu pöörata, on fosfor, kaalium, vask, mangaan ja tsink. Täiendväetiste valik on lai ning toiteelementide vajaduse väljaselgitamisel on abiks mullaanalüüside tulemused.
Fosfor – taime energiaallikas
- Stimuleerib juurte arengut, parandades seeläbi vee ja toitainete (ka mikroelementide) omastamist.
- On võimeline siduma märkimisväärse koguse kaaliumi, toetades seeläbi kaaliumi omastamist.
- Lehekaudne fosfor on taimedele abiks ajal, mil jahedaga on mullast omastamine pärsitud. Happelistes muldades on fosfor seotud olekus raua- ja alumiiniumiühenditega. Aluselistes muldades takistab kaltsium taimedel fosfori omastamist. Ka sellistel juhtudel on kasu lehtede kaudu väetamisest.
Kaalium – taime elutegevuse regulaator
- Reguleerib taimedes õhulõhede avanemist ja sulgumist ning toetab vastupanuvõimet abiootilisele stressile (temperatuur, veega seotud, osmootne).
- Stimuleerib fotosünteesi aktiivsust.
- Tõstes taimedes suhkrute ja süsivesikute taset, mõjutab taimede talvekindlust.
- Kergema lõimisega muldadest kipub kaalium välja leostuma ning raskema lõimisega muldades võib olla seotud olekus.
Fosfori- ja kaaliumivarude täiendamiseks sobivad tooted on Cropvit PK 3-4 l/ha, ArmoniKa 3-4 l/ha, YaraVita KombiPhos 3 l/ha, Detera PK 2-3 l/ha, Dr Green Kvaliteet 1 kg/ha + Dr Green Teravili 2 kg/ha.
Vase poolest on Eesti mullad küllaltki vaesed. Vask soodustab võrsumist ning pritsimine tuleb teraviljadel ära teha kindlasti võrsumise faasis, sest hiljem pritsides on kasutegur madal. Vase puudusel võib saagikadu ulatuda kuni 1,5 t/ha. Soovitus on taliviljade, eriti talinisu puhul vasega pritsimist alustada juba sügisel ja korrata kevadel.
Kui mullaanalüüside põhjal on muude elementide sisaldus paigas ja vaja oleks korrigeerida vaid vaske, siis soovitame sügisel kasutada Tradecorp Cu 0,75 kg/ha või YaraVita Coptrac 0,5 l/ha.
Mangaan on samuti oluline mikroelement võrsumise soodustamiseks, lisaks on mangaanil oluline roll täita talvekindluse ning haiguskindluse tagamisel. Mangaani puudusele eriti tundlikuks kultuuriks on oder. Soovitatav on taliviljade, eriti odra puhul mangaaniga pritsimist alustada juba sügisel ja korrata kevadel.
Kui mullaanalüüside põhjal on muude elementide sisaldus paigas ja vaja oleks korrigeerida vaid mangaani, siis soovitame kasutada tooteid Tradecorp Mn 0,75 kg/ha või YaraVita Mantrac Pro 0,5 l/ha.
Kui vase ja mangaani sisaldus mullas on teadmata, siis tasub meeles pidada, et tavaliselt esineb puudus kergetel liivastel muldadel ja turbamuldades. Lisaks pärsib vihmane ja külm ilm oluliste elementide kättesaadavust mullast.
Kui mikroelementide sisaldus mullas on määramata jäänud, siis soovitame kasutada universaalsemaid leheväetiseid, mis sisaldavad lisaks vasele ja mangaanile ka teisi teraviljale olulisi elemente. Head lahendused on Dr Green Teravili 2 kg/ha, YaraVita Gramitrel 1-1,5 l/ha, YaraVita Mancozin 1 l/ha, ZM Grow 2-3 l/ha või ZMC Grow 2-3 l/ha.



